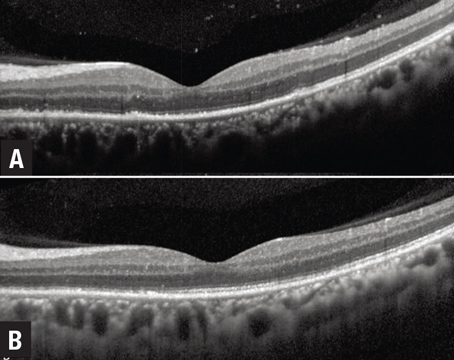
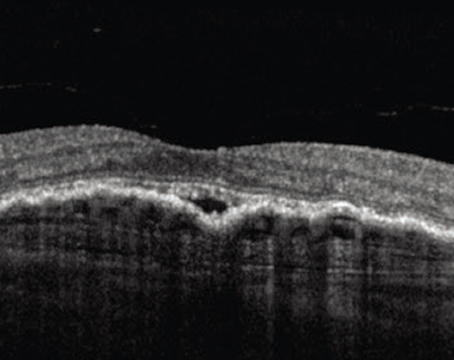

May / June 2022
Features

Can you recognize these novel OCT signs?
A review of characteristic optical coherence tomography findings that can help narrow or even confirm a novel diagnosis.
OCT biomarkers in uveitis: An update
A review of currently used findings that can help predict disease activity and functional response.

What’s coming in therapies for diabetic retinopathy
Dosing tweaks, emerging delivery systems, biosimilars and gene therapy are changing the treatment paradigm.
What’s the potential for home-based OCT?
A feasibility study showed patients could set up the device themselves and capture quality scans.
Departments
Coding Commentary
How not to suffer retractions
Fastidious preoperative documentation will prove to payers you did the surgery.
Editor's Page
Imaging Forum
A ser(i)ous detachment
How multimodal imaging and systemic examination helped uncover the underlying etiology of a longstanding choroidal neovascular membrane.
News
Social Media Specialist
Burnish your online presence
A look at three essential tools that can boost your social media productivity.
Surgical Pearl Video
Subretinal blebs, sans retinotomy
This atraumatic technique uses a soft-tip on proportional reflux for creating subretinal fluid blebs.
Uveitis Forum
Treating uveitic macular edema
A review of local and systemic treatments for UME and insights on when to use them.



